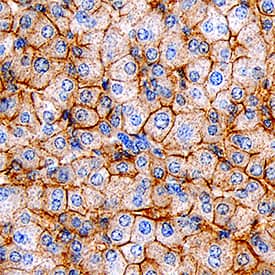
SR-BI antibody in Human Liver by Immunohistochemistry (IHC-P).

Human SR-BI Antibody
R&D Systems, part of Bio-Techne | Catalog # MAB8114


Key Product Details
Species Reactivity
Applications
Label
Antibody Source
Product Specifications
Immunogen
Specificity
Clonality
Host
Isotype
Scientific Data Images for Human SR-BI Antibody
Detection of Human SR-BI by Western Blot.
Western blot shows lysates of human liver tissue and human adrenal gland tissue. PVDF membrane was probed with 2 µg/mL of Mouse Anti-Human SR-BI Monoclonal Antibody (Catalog # MAB8114) followed by HRP-conjugated Anti-Mouse IgG Secondary Antibody (Catalog # HAF018). A specific band was detected for SR-BI at approximately 80 kDa (as indicated). This experiment was conducted under reducing conditions and using Immunoblot Buffer Group 1.SR-BI in Human Liver.
SR-BI was detected in immersion fixed paraffin-embedded sections of human liver using Mouse Anti-Human SR-BI Monoclonal Antibody (Catalog # MAB8114) at 15 µg/mL overnight at 4 °C. Tissue was stained using the Anti-Mouse HRP-DAB Cell & Tissue Staining Kit (brown; Catalog # CTS002) and counterstained with hematoxylin (blue). Specific staining was localized to cell membranes in hepatocytes. View our protocol for Chromogenic IHC Staining of Paraffin-embedded Tissue Sections.Applications for Human SR-BI Antibody
Immunohistochemistry
Sample: Immersion fixed paraffin-embedded sections of human liver
Western Blot
Sample: Human liver tissue and human adrenal gland tissue
Reviewed Applications
Read 1 review rated 4 using MAB8114 in the following applications:
Formulation, Preparation, and Storage
Purification
Reconstitution
Formulation
Shipping
Stability & Storage
- 12 months from date of receipt, -20 to -70 °C as supplied.
- 1 month, 2 to 8 °C under sterile conditions after reconstitution.
- 6 months, -20 to -70 °C under sterile conditions after reconstitution.
Background: SR-BI
Scavenger Receptor, class B, member 1 (SR-B1), gene name SCARB1, is also known as CD36L1 (CD36-like 1) or CLA-1 (CD36 and LIMPII analogous 1) (1-5). SR-B1 is a transmembrane glycoprotein found on macrophages, liver cells and other steroidogenic cells as a lipoprotein receptor. The 552 amino acid (aa) human SR-B1 contains a central extracellular domain (ECD), flanked by N- and C-terminal transmembrane domains. Human splice variants differ at the N-terminal cytoplasmic and transmembrane domains (SR-BIII, 474 aa), the N-terminal end of the ECD (SR-BII, 409 aa), or the C-terminal cytoplasmic domain (isoform 3, 552 aa) (2). The human SR-B1 ECD shares 80%, 80%, 89%, 86% and 84% aa sequence identity with mouse, rat, porcine, rabbit, and bovine SR-B1, respectively. SR-B1 functions in reverse cholesterol transport (RCT), which is thought to be anti-atherogenic by facilitating transport of cholesteryl esters from macrophages back to the liver for degradation (3). In rodent hepatocytes, SR-B1 is the main receptor mediating RCT, while human hepatocytes also express a second mediator, CETP (cholesteryl ester transfer protein) (3-5). The importance of SR-B1 in humans is shown by human SR-B1 genetic variants that alter lipid metabolism (3-7). For example, the P297S polymorphism lowers uptake of high-density lipoprotein (HDL) cholesterol in the liver and increases plasma HDL cholesterol (3-5). On endothelial cells, signaling through SR-B1 activates nitric oxide production, which attenuates monocyte adhesion (6). On adrenocortical cells, SR-B1 mediates uptake of cholesteryl esters from HDL for the synthesis of glucocorticoid hormones such as cortisol (3-5). On platelets, HDL binding to surface SR-B1 inhibits aggregation and increases platelet survival time (3-5). On human ovarian granulosa cells, deficiency of SR-B1 correlates with low fertility (3). SR-B1 and its SR-BII isoform also bind bacterial lipopolysaccharides, facilitating uptake of various bacteria by cells such as peritoneal macrophages (8, 9). This uptake enhances inflammatory responses which, unless properly controlled, can result in sepsis (9-11).
References
- Calvo, D. and M. A. Vega (1993) J. Biol. Chem. 268:18929.
- Swiss-Prot accession Q8WTV0
- Chadwick, A.C. and D. Sahoo (2013) Curr. Opin. Endocrinol. Diabetes Obes. 20:124.
- Hoekstra, M. et al. (2012) Curr. Opin. Lipidol. 23:127.
- Vergeer, M. et al. (2011) N. Engl. J. Med. 364:136.
- Guo, L. et al. (2011) J. Lipid Res. 52:2272.
- Saddar, S. et al. (2012) Circ. Res. 112:140.
- Vishnyakova, T.G. et al. (2006) Proc. Natl. Acad. Sci. USA 103:16888.
- Baranova, I.N. et al. (2012) J. Immunol. 188:1371.
- Leelahavanichkul, A. et al. (2012) J. Immunol. 188:2749.
- Guo, L. et al. (2009) J. Biol. Chem. 284:19826.
Long Name
Alternate Names
Gene Symbol
Additional SR-BI Products
Product Documents for Human SR-BI Antibody
Product Specific Notices for Human SR-BI Antibody
For research use only